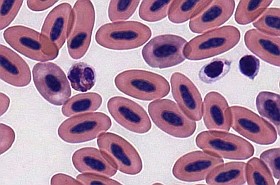
Aszpirinnel védekezik a trombózis ellen? Nem biztos, hogy használ!

Az aszpirin régóta kedvelt terápia az artériás trombózis megelőzése céljából. Bár sok esetben valóban hatásosnak bizonyul, ám nem ritka, amikor az illető nem reagál a kezelésre. Az aszpirin rezisztenciáról prof. Blaskó Györgyöt, a Trombózisközpont véralvadási specialistáját kérdeztük.
Így hat az aszpirin
Aszpirinnel védekezik a trombózis ellen? Nem biztos, hogy használ!
Forrás: Sajtóközlemény
Bár az aszpirint szélesebb körben elsősorban láz-és fájdalomcsillapítóként ismerik, ám kutatások szerint sokaknál hatékony megelőzést nyújt a vérrögök okozta szívinfarktus és stroke ellen is. Az artériás trombózis hátterében a legfontosabb tényezők egyike a vérlemezkék összecsapódása, melyért az erekben lévő plakk felhasadása (un. ruptúrája) a felelős. A plakk miatt az ér keresztmetszete szűkül, melynek eredményeként megnő benne a vér keringési sebessége, tehát megnő a vérnyomás. Ennek hatására az érbelső, endothel részén sérülések keletkeznek, mely a vérlemezkék összecsapódását váltja ki.
Az aszpirin (acetilszalicilsav) ezt az összecsapódást hivatott megakadályozni, ez ugyanis meggátolja egy fontos enzim, a COX1 működését. A COX1 enzim a vérlemezkéken és az endothel sejteken belül az arachidonsav anyagcsere egyik fontos enzimje, tevékenysége következtében az arachidonsavból olyan un. prosztaglandinok keletkeznek, amik összecsapják a vérlemezkéket. (de az érfalban képződik belőle az összecsapzódást gátló prosztaciklin nevű anyag, így biztosítva az aggregáció/aggregációgátlás egyensúlyát.
Nem véd minden esetben
Sajnos hiába az aszpirin több pozitív tulajdonsága, van, hogy szedése ellenére is kialakulnak vérrögök. Ennek hátterében legtöbbször aszpirin rezisztencia, vagy un. non-responsio áll, mely során nagy valószínűséggel a COX1 enzim szerkezete változik olyanná (bár ezen a téren még további vizsgálatok folynak), hogy a vérlemezkék összecsapódását nem akadályozza meg a terápia. A hatástalanságot természetesen fokozza például a kevés folyadékfogyasztás, dohányzás, helytelen táplálkozás, illetve a kezeletlen magasvérnyomás - mondja prof. Blaskó György, a Trombózisközpont véralvadási specialistája.
Vizsgálattal kideríthető
Hogy kideríthető legyen, vajon kinél áll fenn aszpirin rezisztencia, érdemes egy speciális laborvizsgálaton részt venni. Ehhez egy egyszerű vérvétel szükséges, majd a vért egy speciális készülékbe rakják, és figyelik, hogy a benne lévő speciális anyagokkal átitatott membrán miként záródik el a kicsapódó vérlemezkéktől. Amennyiben aszpirin rezisztenciát igazolnak, úgy sokszor az adag emelésével el lehet érni jobb hatást, ám eredményesebb, ha az aszpirint egy másik vérlemeze-összecsapódást gátló készítménnyel helyettesítik ( pl. clopidogrel).
Forrás: Trombózisközpont
Kövesse az Egészségkalauz cikkeit a Google Hírek-ben, a Facebook-on, az Instagramon vagy a X-en,Tiktok-on is!








